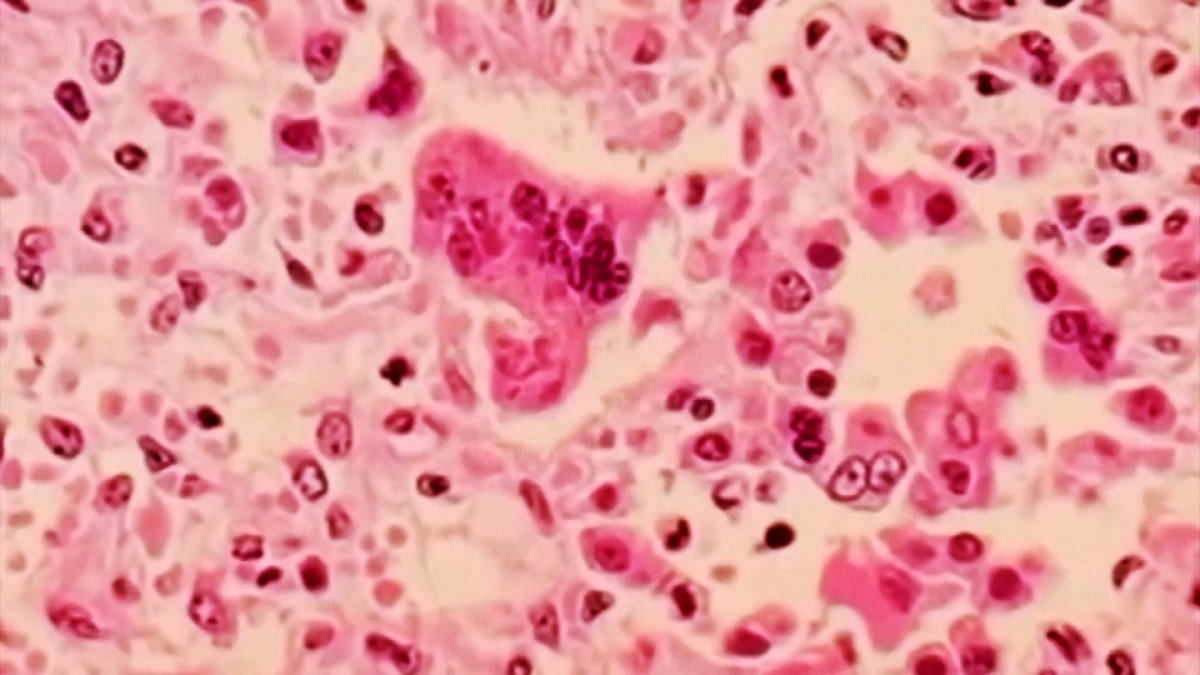

1d ago
References
Measles exposure risk for anyone who visited Mall of America evening of May 24

CDC updates travel warning for highly contagious disease as cases rise

New Travel Warning Issued By CDC As Measles Cases Rise

CDC urging travelers to be vaccinated against measles
US counties where world's most infectious disease is set to surge

CDC urging travelers to be vaccinated against measles

Measles Vaccination Rates Are Plummeting Across the U.S.

Two more Colorado measles infections connected to out-of-state traveler

Measles Update: Where Are We Now?

Warning of overseas outbreaks, CDC urges Americans to get the measles vaccine before traveling abroad

A child had measles at Mall of America, concerning state health officials who don’t know source

Two more measles cases in Minnesota, including unvaccinated child who was infectious at MOA

Logan Health forms Measles Incident Command Team

0 Comments
Be the first to comment
Add your thoughts and get the conversation going.
Top 4,946 Internet News Today
Explore Your Interests
Create an account and enjoy content that interests you with your personalized feed
Unlimited Access
Personalized Feed
Full Experience
By continuing, you agree to the Privacy Policy.. You also agree to receive our newsletters, you can opt-out any time.